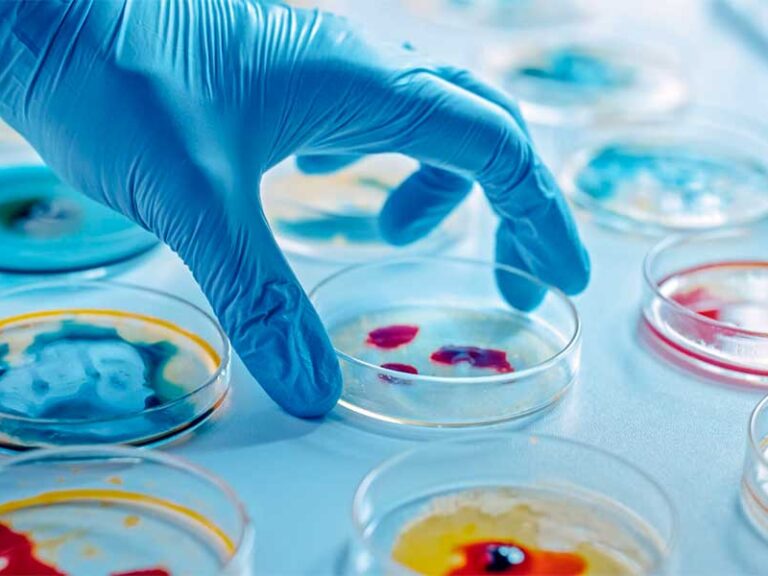

Impulsan capacitación en acuacultura para fortalecer producción en Hidalgo
Más de 500 acuicultores(as) de Hidalgo fueron capacitados en nutrición y manejo de peces, fortaleciendo sus procesos productivos, reduciendo costos y promoviendo prácticas sostenibles para mejorar la rentabilidad y el…